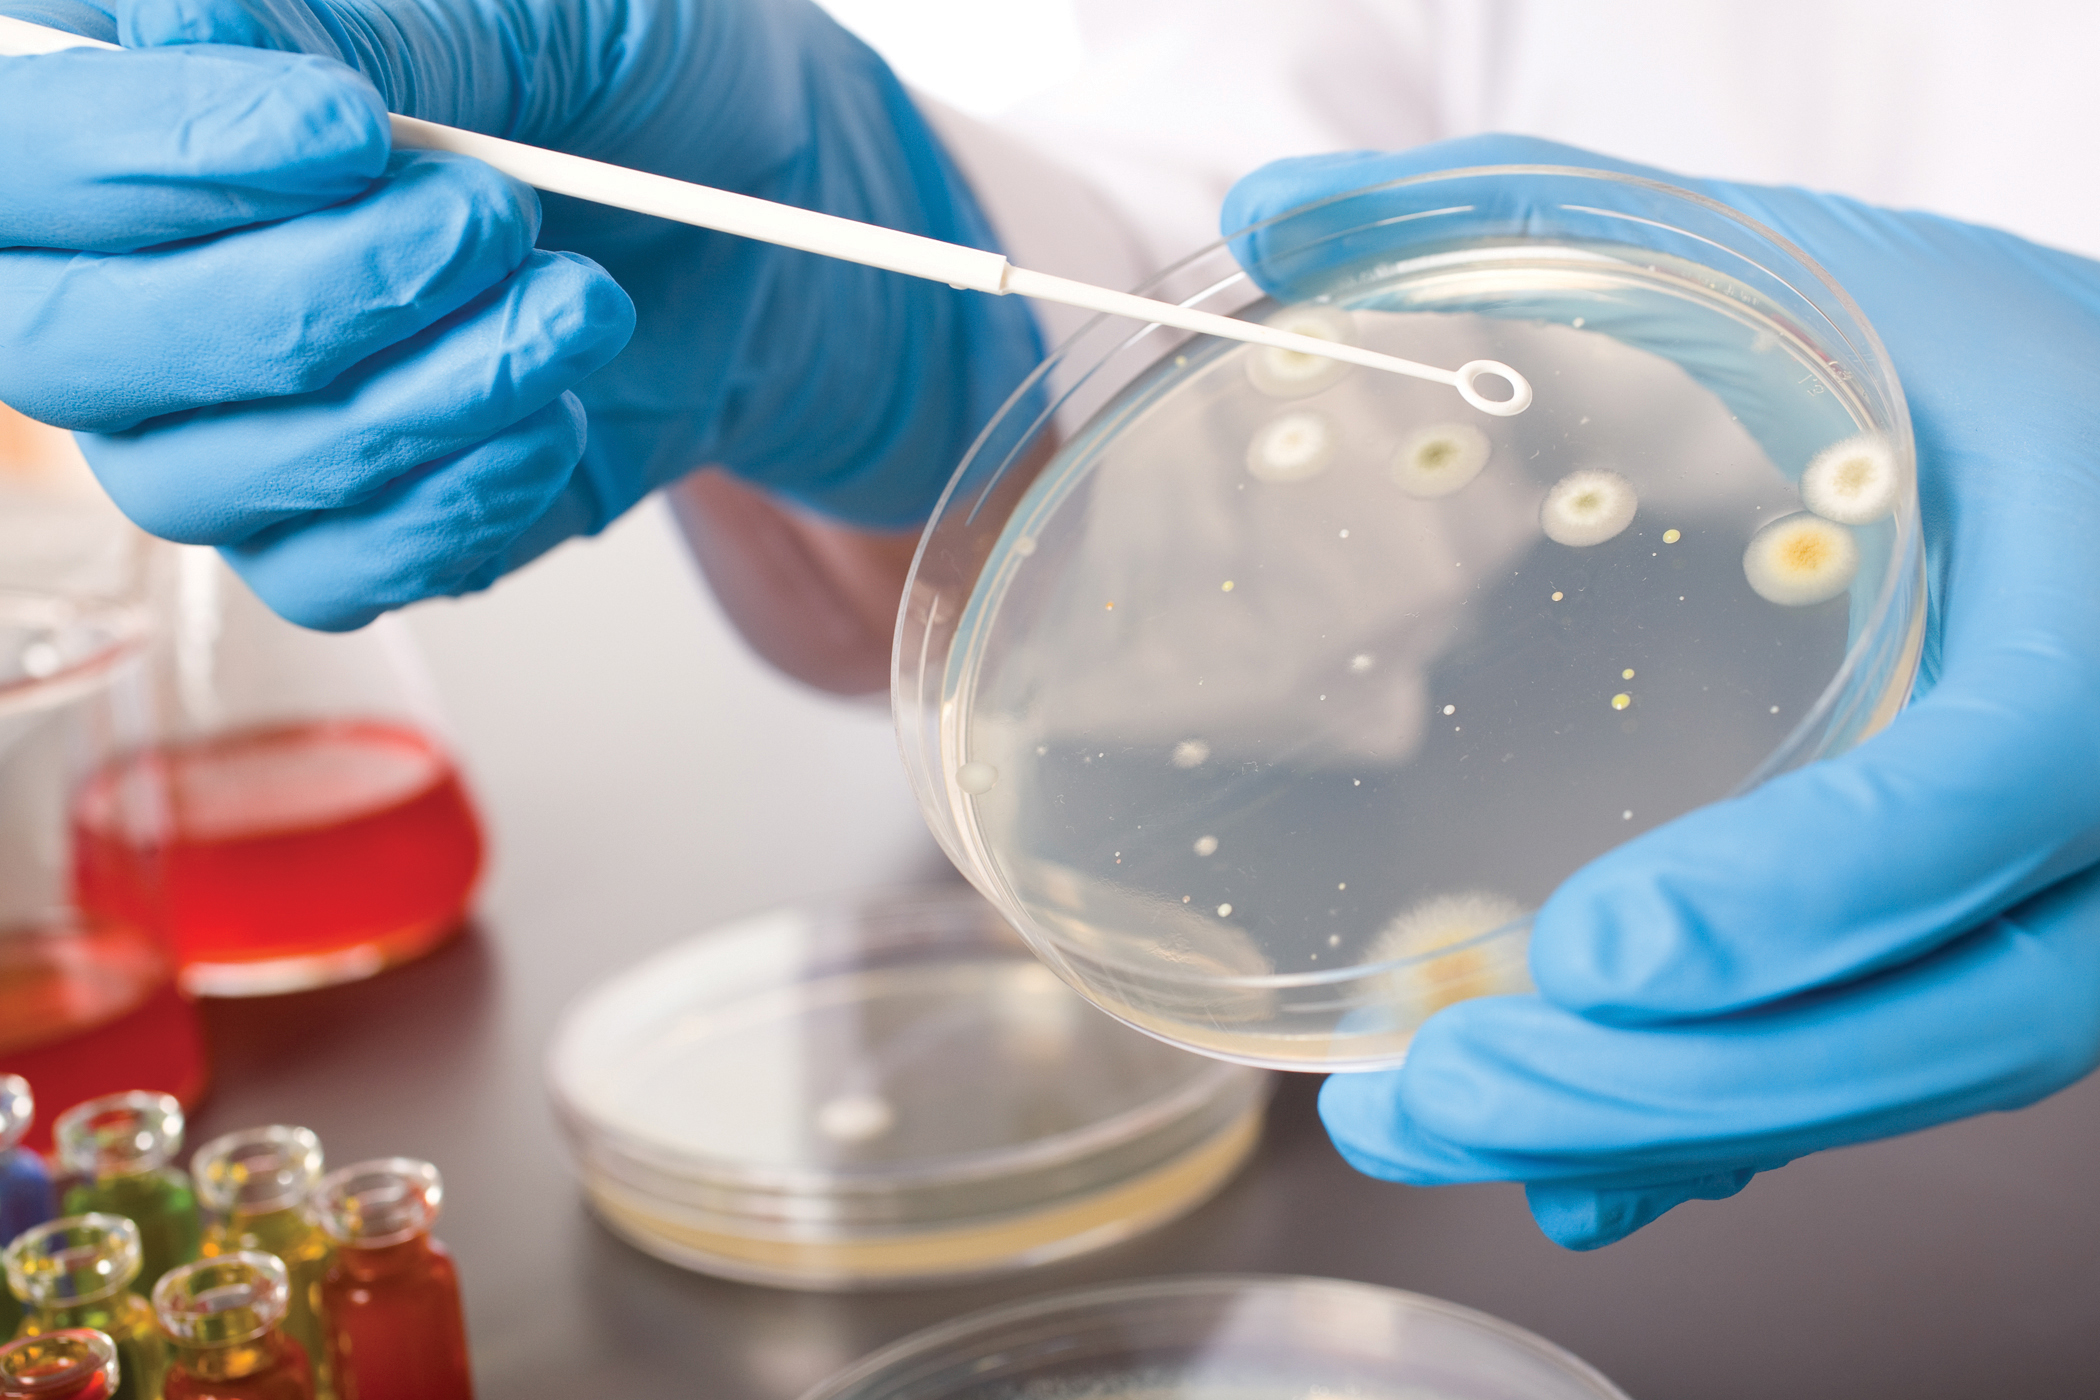

Vaccini
Cellule fetali nei vaccini, il dottor Montanari risponde alle polemiche
Come scritto nell’articolo precedente, Renovatio 21 pubblica questa intervista in cui Stefano Montanari risponde alla polemica innescata dal prof. Lopalco e dai suoi compagni.
Seguendo il ragionamento degli accusatori del dottor Montanari, un medico antimafia dovrebbe rifiutarsi di fare l’autopsia ai morti per mano della mafia. Anzi, di più: è mafioso il medico che fa l’autopsia degli ammazzati dalla mafia. Ricordiamo inoltre che studi autoptici sui feti abortiti A) non sempre sono a fine di lucro (quelli delle farmaceutiche che essi difendono lo sono) e B) talvolta possono essere non solo utili, ma pure necessari: gli studi avvenuti in Germania sugli aborti del caso del disastro di Seveso provarono che i feti erano sani, e qui si apre una grande parentesi sulla storia nazionale.
Un parentesi che però chiudiamo subito, perché non siamo sicuri che Lopalco & Co possano seguirci sul terreno della bioetica. Ciò detto, abbiamo già fatto in passato incontri a due voci, invitando a parlare dottori vaccinisti, nel massimo della civiltà e della correttezza. Saremmo lieti di fare un incontro sul tema anche con Lopalco e i suoi amici, non hanno che da farcelo sapere.
Dott. Montanari, le accuse avanzate a lei dal Prof. Lopalco, dal Prof. Bucci, e dal Prof. Conte a proposito dell’utilizzo di feti abortiti per un lavoro diretto da lei e sua moglie nel 2011 corrispondono al vero?
Siamo molto oltre la farsa: siamo alla noia. Io capisco che quei signori pensino di godere di un pubblico non solo impreparato ma ormai addestrato ad ingurgitare qualunque cosa, ma prima o poi qualcuno si accorgerà di quanto la gente sia presa per i fondelli. Nel caso in questione, si trattava di reperti anatomo-patologici di feti conservati nell’archivio del reparto di anatomia patologica dell’Università di Modena e Reggio.
«Prima o poi qualcuno si accorgerà di quanto la gente sia presa per i fondelli»
Bene, partiamo da questo per spiegare nel dettaglio il perché. Anzitutto: avete commissionato o voluto voi quegli aborti?
Il solo pensare una cosa del genere è grottesco. A parte qualunque considerazione, aborti volontari commissionati non avrebbero fornito niente di utile e dunque, avrebbero solo comportato problemi.
Dopo quanto tempo dagli aborti compiuti avete analizzato questi tessuti?
Si trattava di campioni archiviati dall’Università e non ho la più pallida idea di quando fossero arrivati.
Quindi, in un certo senso, voi siete stati gli ultimi ad arrivare?
Noi siamo arrivati su campioni di archivio richiesti non sappiamo quando dalle famiglie o dalle procure o dall’ospedale. Questo accade quando ci siano indicazioni cliniche.
Chi vi chiese di fare delle ricerche e per quale motivo?
Fu parte di un progetto europeo di ricerca nanotossicologica. I nostri dati facevano parte integrante di una cosiddetta «in-field evaluation».
Le fandonie più ridicole e più facilmente smentibili da chi solo si prendesse la briga di controllare trovano ampio credito e permettono la perpetuazione di qualcosa sulla cui onestà e sulla cui moralità non credo sia necessario spendere parole
Nessuno scopo di produzione farmaceutica postuma attraverso questi tessuti, quindi?
Certamente no: nulla a che fare con qualunque interesse economico di chicchessia.
Insomma, su che cosa avete lavorato?
Come ho detto, il lavoro fu effettuato su campioni dei tessuti autoptici inglobati in paraffina, come qualunque medico sa o, almeno, dovrebbe sapere.
Voi allora, direttamente, non c’entrate nulla con l’origine dell’aborto dei feti e con le eventuali motivazioni legate a quest’ultimo, vero?
Ovviamente no. Al reparto di anatomia patologica non arriva nemmeno la cartella clinica. Arriva solo una richiesta in cui si chiede di capire di più sul reperto inviato. L’anatomo-patologo fa tutte le preparazioni istologiche dei reperti prelevati dal medico legale e le osservazioni di sua competenza per poter rispondere.
Anche da un punto di vista etico e morale, allora – che è proprio quello che il trio vorrebbe mettere, facendolo passare per incoerente, all’attenzione dei lettori – non c’è alcuna responsabilità da parte vostra.
La stessa responsabilità che ha un anatomo-patologo quando si trova ad indagare su un cadavere.
Le accuse del trio sono allora non solo infondate, ma anche sconnesse dalla realtà dei fatti?
Una pagliacciata, non so se in malafede o nell’incapacità di capire ciò di cui si parla.
I feti usati per i vaccini sono tutt’altro. Sono prelevati in vivo e mantenuti vitali a scopo industriale.
Ma veniamo al punto forte che dobbiamo spiegare a chi ci legge: quali sono le differenze fra la produzione di vaccini con linee cellulari di feti abortiti, anche se il feto utilizzato per ottenere la linea oggi più comune (MRC-5) è stato abortito 53 anni fa, e il vostro studio condotto nel 2011?
Non c’è niente in comune. Il nostro era uno studio meramente scientifico effettuato su campioni autoptici già analizzati dall’anatomo-patologo che fa il mestiere che è chiamato a svolgere. I feti usati per i vaccini sono tutt’altro. Sono prelevati in vivo e mantenuti vitali a scopo industriale.
Così stando le cose, sembrerebbe che gli illustri professori non abbiano nemmeno avuto il buon senso di verificare le differenti modalità di utilizzo dei feti e gli scopi…
Bisogna in qualche modo capirli. Si tratta di signori catapultati alla ribalta che forniscono giustificazioni ad una pratica che per il mio giudizio è impossibile non qualificare come criminale oltre che pericolosa per la salute di chi subisce le vaccinazioni. Forti di un regime che non conosce limiti economici, questi tre signori, del resto come tanti altri, possono avvalersi di un sistema di comunicazione capillare e martellante. In quella maniera le fandonie più ridicole e più facilmente smentibili da chi solo si prendesse la briga di controllare trovano ampio credito e permettono la perpetuazione di qualcosa sulla cui onestà e sulla cui moralità non credo sia necessario spendere parole. Se quei tre soggetti abbiano capito l’articolo che costituisce il bersaglio del loro sproloquio è cosa che non so.
Negano anche, rimandando ad un altro articolo, che ci sia stato più di un aborto per la ricerca farmaceutica. Ma lo scandalo della Planned Parenthood, noto a tutto il mondo ma evidentemente non ai tre, non dice qualcosa di leggermente diverso?
Mi sembra di assistere ad una delle scenette più comuni nell’avanspettacolo di decenni fa quando il marito, rincasando, trovava l’amante della moglie nascosto nell’armadio e la moglie giurava, creduta, che si trattasse di un signore che aspettava l’autobus. Quando si ha a che fare con interlocutori che si crede essere al di sotto di un certo livello, negare l’evidenza è una tecnica vincente. Comportamenti del genere squalificano chi ne è protagonista ma non pare che la cosa interessi. Tra parentesi, proprio ora il governo USA ha ritirato ogni accordo con Planned Parenthood.
Quando si ha a che fare con interlocutori che si crede essere al di sotto di un certo livello, negare l’evidenza è una tecnica vincente
Può ribadirci ancora una volta, nel caso in cui sfuggisse a qualcuno, perché lei critica il silenzio che c’è da parte di istituzioni religiose e credenti di vario tipo sulla massiva inoculazione di vaccini prodotti con linee cellulari di feti abortiti?
È nient’altro che coerenza. Qualcuno in ambito religioso ha stabilito che abortire volontariamente è non solo un peccato, ma il più grave dei peccati mortali. È detto e scritto infinite volte. Che lo scopo di lucro cancelli la colpa mi pare a dir poco curioso. Difendere questo assunto che a me, uomo della strada, pare indifendibile, per di più usando il silenzio o una retorica che mi pare offensiva nei riguardi non solo della fede ma anche dell’intelligenza dei fedeli è cosa che deve essere spiegata in termini razionali. Al di là di ogni considerazione religiosa che non mi riguarda, ora qualunque donna cattolica si sentirà autorizzata ad abortire volontariamente come e quando desidera e sarà interessante vedere a che titolo sarà spedita all’inferno. Se la legge è uguale per tutti, credo sia corretto che lo sia anche la sua applicazione. Forse la Chiesa dovrebbe interrogarsi come sta facendo ora su altri temi, e farlo senza sconti e senza ipocrisie. Non mi pare che con la religione si contratti.
Cristiano Lugli
Gravidanza
Molte donne incinte sono state costrette a vaccinarsi contro il COVID. Ecco cosa è successo

Renovatio 21 traduce questo articolo per gentile concessione di Children’s Health Defense. Le opinioni degli articoli pubblicati non coincidono necessariamente con quelle di Renovatio 21.
I contenuti del vaccino COVID-19 vengono biodistribuiti nel flusso sanguigno in poche ore e attraversano «tutte le barriere fisiologiche, tra cui la barriera materno-placentare-fetale e le barriere ematoencefaliche sia nella madre che nel feto», spiega l’esperto di medicina materno-fetale, Dr. James Thorp.
Mentre un normale vaccino deve essere sottoposto a 10-12 anni di sperimentazioni prima di essere rilasciato, durante la pandemia le vaccinazioni COVID-19 sono state rese disponibili al pubblico solo 10 mesi dopo lo sviluppo, per gentile concessione di un’autorizzazione all’uso di emergenza.
Anche le donne incinte sono state sottoposte alle iniezioni e in molti casi sono state obbligate a riceverle.
«La spinta di questi vaccini sperimentali COVID-19 a livello globale è la più grande violazione dell’etica medica nella storia della medicina, forse dell’umanità», ha detto a Tucker Carlson il dottor James Thorp, esperto di medicina materno-fetale.
Thorp e colleghi hanno pubblicato uno studio di preprint che ha rilevato rischi sorprendenti per le donne in gravidanza che hanno ricevuto le iniezioni, insieme ai loro bambini non ancora nati.
I risultati sono stati così disastrosi che i ricercatori hanno concluso che le donne in gravidanza non dovrebbero ricevere vaccini COVID-19 fino al completamento di ulteriori ricerche.
I ricercatori hanno spiegato:
«Si consiglia una moratoria mondiale sull’uso dei vaccini COVID-19 in gravidanza fino a quando gli studi prospettici randomizzati non documenteranno la sicurezza in gravidanza e il follow-up a lungo termine nella prole».
Vaccini COVID legati a un rischio 27 volte maggiore di aborto spontaneo
Thorp e colleghi hanno utilizzato i dati del Vaccine Adverse Events Reporting System (VAERS) dei Centers for Disease Control and Prevention (CDC) per valutare gli eventi avversi vissuti dalle donne in età riproduttiva dopo aver ricevuto un vaccino COVID-19, rispetto alla ricezione di un vaccino antinfluenzale.
Rispetto al vaccino antinfluenzale, i vaccini COVID-19 sono stati associati a un aumento significativo degli eventi avversi (AE), tra cui:
- Anomalie mestruali
- Aborto
- Anomalie cromosomiche fetali
- Malformazione fetale
- Igroma cistico fetale
- Disturbi cardiaci fetali
- Aritmia fetale
- Arresto cardiaco fetale
- Malperfusione vascolare fetale
- Anomalie della crescita fetale
- Sorveglianza fetale anormale
- Trombosi placentare fetale
- Riduzione del fluido amniotico
- Morte fetale/natimortalità
I ricercatori hanno osservato:
«Quando normalizzati in base al tempo disponibile, alle dosi date o alle persone ricevute, tutti gli eventi avversi del vaccino COVID-19 superano di gran lunga il segnale di sicurezza su tutte le soglie riconosciute… La gravidanza e le anomalie mestruali sono significativamente più frequenti dopo le vaccinazioni COVID-19 rispetto a quelle influenzali».
In particolare, i dati hanno rivelato un rischio 27 volte più elevato di aborto spontaneo e un rischio più che doppio di esiti fetali avversi in sei diverse categorie, secondo l’internista e cardiologo certificato Dr. Peter McCullough.
Le infermiere sono diffidate dal parlare?
I problemi hanno iniziato ad apparire poco dopo che sono stati lanciati i vaccini COVID-19, con un’e-mail trapelata da un grande ospedale della California inviata in avvertimento a 200 infermieri.
L’e-mail, del settembre 2022, conteneva come oggetto «Gestione della morte», che si riferiva a un aumento dei nati morti e delle morti fetali.
Un servizio TCW della giornalista Sally Beck ha condiviso il contenuto dell’e-mail, che recitava:
«Sembra che l’aumento dei pazienti deceduti [bambini] che stiamo vedendo continuerà. Ci sono stati 22 decessi [nati morti e morti fetali] ad agosto [2022], il che equivale al numero record di decessi nel luglio 2021, e finora a settembre [2022] ce ne sono stati 7 ed è solo l’ottavo giorno del mese».
Beck riferisce che a un’infermiera, Michelle Gershman, che lavora nel reparto neonatale, è stato negato il bonus perché ha parlato dell’aumento delle morti fetali.
«Avevamo un decesso fetale al mese. Poi è salito a uno o due a settimana», ha detto Gershman.
«La sua esperienza, e l’esperienza dei medici che lavorano con donne in gravidanza, è contraria all’osservazione e ai consigli ufficiali sicuri ed efficaci, ma nessuno era libero di parlare a causa di una diffida imposta nel settembre 2021 dall’American Board of Obstetrics and Gynecology (ACOG)» ha raccontato la Beck.
«All’inizio del lancio, nel dicembre 2020, le donne incinte che erano operatrici sanitarie o ritenute a rischio di COVID hanno iniziato a ricevere le iniezioni. A maggio 2021, il vaccino veniva raccomandato a tutte le donne americane in gravidanza, nonostante nessuno dei produttori di vaccini avesse completato i rapporti di tossicologia riproduttiva negli animali e nessuno avesse iniziato studi clinici su donne in gravidanza».
«Due mesi dopo, gli ospedali hanno notato un enorme aumento di aborti spontanei, nati morti, nascite pretermine, complicazioni della gravidanza e anomalie mestruali».
I vaccini COVID dovrebbero essere di categoria X
Secondo McCullough, l’mRNA dei vaccini COVID-19 circola nel corpo per 28 giorni o più e la proteina spike può innescare coagulazione, sanguinamento e danni ai tessuti.
A causa di questa e di altre preoccupazioni, afferma che, in modo prudente, le iniezioni di COVID-19 dovrebbero ricevere la designazione «Categoria X» durante la gravidanza, il che significa che «il rischio dell’uso del farmaco nelle donne in gravidanza supera chiaramente ogni possibile beneficio. Il farmaco è controindicato nelle donne che sono o potrebbero rimanere incinte».
Sfortunatamente, i funzionari sanitari negli Stati Uniti continuano ad affermare la sua sicurezza, anche per popolazioni fragili come questa, come hanno fatto fin dall’inizio.
«Incredibilmente, nella primissima settimana di vaccinazione di massa nel dicembre del 2020», ha scritto McCullough, «i notiziari hanno raffigurato madri incinte ben intenzionate a cui sono state iniettate nanoparticelle lipidiche sintetiche intrecciate con mRNA di lunga durata codificante per la proteina Spike dell’Istituto di virologia di Wuhan».
Lo studio di Thorp ha anche riferito che i dati di Pfizer hanno mostrato che i contenuti delle iniezioni di COVID-19 vengono biodistribuiti nel flusso sanguigno in poche ore e attraversano «tutte le barriere fisiologiche tra cui la barriera materno-placentare-fetale e le barriere ematoencefaliche sia nella madre che nel feto».
Uno studio separato sta, infatti, esaminando l’utilizzo di nanoparticelle lipidiche ionizzabili (LPN) come quelle utilizzate come piattaforme di rilascio di mRNA nelle iniezioni di COVID-19, come strumenti per somministrare farmaci alla placenta, perché sono così efficaci nel raggiungerla.
«Gli LNP migliorano la stabilità dell’mRNA, il tempo di circolazione, l’assorbimento cellulare e la consegna preferenziale a tessuti specifici rispetto all’mRNA senza piattaforma portante», hanno scritto i ricercatori.
Ma lo studio contiene alcuni dati preoccupanti, che sono stati condivisi su Twitter:
I funzionari sanitari hanno affermato che i vaccini COVID-19 sono sicuri ed efficaci per le donne in gravidanza sulla base di uno studio di 42 giorni di Pfizer che ha coinvolto 44 ratti.
Inoltre, lo studio sui ratti Pfizer-BioNTech ha rivelato che l’iniezione ha più che raddoppiato l’incidenza della perdita preimpianto e ha anche portato a una bassa incidenza di malformazioni della bocca/mascella, gastroschisi (un difetto alla nascita della parete addominale) e anomalie nell’arco aortico destro e nelle vertebre cervicali nei feti.
«In quello studio il tasso di perdita fetale è RADDOPPIATO (dal 4,2% al 9,8%) ma ha avuto un impatto limitato sul numero complessivo di feti», ha twittato Jikkyleaks, condividendo il grafico sopra.
Il tweet continua:
«È così che queste informazioni vengono nascoste. Quella singola diapositiva avrebbe dovuto essere sufficiente a richiedere molte più indagini, perché mostrava meno feti in OGNI GRUPPO».
Scioccante calo dei tassi di natalità dopo i vaccini Covid
I tassi di natalità in vari Paesi europei sono diminuiti significativamente alla fine del 2021, mesi dopo che i vaccini COVID-19 sono stati ampiamente utilizzati.
I dati, compilati da un team di ricercatori europei, hanno rilevato cali dei tassi di natalità in tutti i Paesi studiati, tra cui:
- Germania
- Austria
- Svizzera
- Francia
- Belgio
- Paesi Bassi
- Danimarca
- Estonia
- Finlandia
- Lettonia
- Lituania
- Svezia
- Portogallo
- Spagna
- Repubblica Ceca
- Ungheria
- Polonia
- Romania
- Slovenia
- Islanda
- Irlanda del Nord
- Montenegro
- Serbia
Il team ha spiegato:
«Prima di tutto va notato che ogni singolo paese europeo esaminato mostra un calo mensile dei tassi di natalità fino a oltre il 10% rispetto agli ultimi tre anni. Si può dimostrare che questo segnale molto allarmante non può essere spiegato da infezioni COVID-19.
«Tuttavia, si può stabilire una chiara correlazione temporale con l’incidenza delle vaccinazioni COVID nella fascia di età di uomini e donne tra i 18 e i 49 anni. Pertanto, devono essere richieste analisi statistiche e mediche approfondite».
Il calo dei tassi di natalità variava da un minimo dell’1,3% in Francia a un massimo del 19% in Romania.
Sette Paesi hanno registrato un calo del tasso di natalità superiore al 10%, mentre 15 paesi hanno registrato un calo superiore al 4%. Si diceva che il calo della Svizzera avesse superato il calo verificatosi dalla prima guerra mondiale, dalla seconda guerra mondiale, dalla Grande Depressione e dal rilascio di contraccettivi orali.
Non è stata trovata alcuna connessione tra il calo dei tassi di natalità e le infezioni o i ricoveri per COVID-19, con il team che ha osservato:
«Le reazioni avverse relative agli organi riproduttivi femminili e i risultati dello studio relativi alla fertilità maschile indicano un’interpretazione causale dell’associazione tra declino delle nascite e vaccinazioni Covid-19».
I vaccini COVID influenzano i cicli mestruali
Non è noto in che modo le iniezioni di COVID-19 influenzino la salute riproduttiva negli uomini e nelle donne.
Ad esempio, The Vaccine Reaction ha riportato:
«Ad oggi, l’inserto del produttore per i vaccini COVID approvati dalla FDA afferma esplicitamente che non è stato testato per il potenziale di compromettere la fertilità maschile».
Tuttavia, i dati sull’infertilità negli Stati Uniti dopo il lancio dei vaccini COVID non sono disponibili.
Nel frattempo, le donne di tutto il mondo hanno segnalato cambiamenti nei loro cicli mestruali in seguito alle iniezioni di COVID-19 e i funzionari sanitari hanno in gran parte ignorato i rapporti o li hanno etichettati come aneddotici.
Ma uno studio pubblicato su Obstetrics & Gynecology — e finanziato dal National Institute of Child Health and Human Development e dal National Institutes of Health Office of Research on Women’ s Health — conferma un’associazione tra la durata del ciclo mestruale e le vaccinazioni COVID-19.
Gli studi clinici per i vaccini COVID-19 non hanno raccolto dati sui cicli mestruali dopo l’iniezione e il VAERS non raccoglie attivamente nemmeno le informazioni sul ciclo mestruale, rendendo difficile determinare inizialmente se le iniezioni stavano avendo un effetto.
I rapporti aneddotici sui social media, tuttavia, sono numerosi e, secondo lo studio, «suggeriscono che i disturbi mestruali sono molto più comuni».
Lo studio di Obstetrics & Gynecology ha coinvolto 3.959 individui di età compresa tra i 18 e i 45 anni. Coloro che non avevano ricevuto il vaccino COVID-19 non hanno notato cambiamenti significativi nel ciclo 4 durante lo studio rispetto ai primi tre cicli.
Tuttavia, coloro che hanno ricevuto i vaccini COVID-19 presentavano cicli mestruali più lunghi quando hanno ricevuto le iniezioni.
I cicli più lunghi sono stati notati per entrambe le dosi dell’iniezione, con un aumento di 0,71 giorni dopo la prima dose e un aumento di 0,91 giorni dopo la seconda dose.
Rilevate modifiche del ciclo di otto giorni o più
Le diminuzioni complessive sono state descritte come clinicamente non significative.
Tuttavia, alcune donne, in particolare quelle che hanno ricevuto due iniezioni nello stesso ciclo mestruale, hanno mostrato cambiamenti significativi, tra cui un aumento di due giorni della durata del ciclo e, in alcuni casi, cambiamenti nella durata del ciclo di otto giorni o più.
Considerando che un ciclo mestruale regolare è «un segno evidente di salute e fertilità», qualsiasi cambiamento potrebbe avere importanti conseguenze.
Inoltre, il team ha osservato: «Rimangono domande su altri possibili cambiamenti nei cicli mestruali, come sintomi mestruali, sanguinamento non programmato e cambiamenti nella qualità e nella quantità del sanguinamento mestruale».
Nel loro insieme, i legami con l’aborto spontaneo, i cambiamenti riproduttivi e il calo dei tassi di natalità sollevano importanti bandiere rosse sulla sicurezza delle iniezioni di COVID-19 per le persone in età riproduttiva.
Pertanto, il team di ricerca europeo ha fatto eco a Thorp nel chiedere una moratoria sulle vaccinazioni COVID-19 per le donne in gravidanza e ha fatto un ulteriore passo avanti suggerendo una sospensione per tutti gli individui in età riproduttiva:
«Data la notevole rilevanza individuale e sociale del legame tra campagne di vaccinazione e calo dei tassi di natalità, dovrebbe essere richiesta l’immediata sospensione della vaccinazione COVID-19 per tutte le persone in età fertile e riproduttiva».
Pubblicato originariamente da Mercola.
Le opinioni espresse in questo articolo sono quelle degli autori e non riflettono necessariamente le opinioni di Children’s Health Defense.
Le opinioni espresse in questo articolo sono quelle degli autori e non riflettono necessariamente le opinioni di Children’s Health Defense.
Renovatio 21 offre questa traduzione per dare una informazione a 360º. Ricordiamo che non tutto ciò che viene pubblicato sul sito di Renovatio 21 corrisponde alle nostre posizioni.
Reazioni avverse
Danno cardiaco subclinico più diffuso di quanto si pensasse dopo la vaccinazione mRNA: nuovo studio

Il danno al cuore è più comune di quanto si pensasse dopo aver ricevuto il booster COVID-19 a base di mRNA, indica un nuovo studio. Lo riporta la testata statunitense Epoch Times.
Un operatore sanitario su 35 in un ospedale svizzero aveva segni di lesioni cardiache associate al vaccino mRNA hanno scoperto i ricercatori.
«L’aumento dei marcatori di danno miocardico associato alla vaccinazione di richiamo mRNA si è verificato in circa una persona su 35 (2,8%), un’incidenza maggiore di quella stimata nelle meta-analisi dei casi ospedalizzati con miocardite (incidenza stimata 0,0035%) dopo il secondo vaccinazione», hanno scritto gli studiosi nel documento, pubblicato dall’European Journal of Heart Failure.
In una popolazione generalmente sana, il livello sarebbe di circa l’1%, hanno detto i ricercatori.
Il gruppo che ha sperimentato gli effetti avversi è stato seguito per soli 30 giorni e la metà aveva ancora livelli insolitamente alti di troponina cardiaca T ad alta sensibilità, un indicatore di danno cardiaco subclinico, al follow-up.
Le implicazioni a lungo termine dello studio rimangono poco chiare poiché poche ricerche hanno monitorato nel tempo le persone con lesioni cardiache dopo la vaccinazione con RNA messaggero, che è noto per causare miocardite e altre forme di danno cardiaco.
«Secondo le attuali conoscenze, il muscolo cardiaco non può rigenerarsi, o solo in misura molto limitata nel migliore dei casi. Quindi è possibile che ripetute vaccinazioni di richiamo ogni anno possano causare danni moderati alle cellule del muscolo cardiaco», ha affermato in una nota il professore dell’ospedale universitario di Basilea Christian Muller, cardiologo e ricercatore capo.
Nessuno dei pazienti ha manifestato un evento cardiaco avverso maggiore, come insufficienza cardiaca, entro 30 giorni dalla vaccinazione di richiamo e nessuno ha avuto alterazioni dell’elettrocardiogramma.
Alle persone con livelli elevati è stato consigliato di evitare un intenso esercizio fisico, che potrebbe aver mitigato problemi più gravi, hanno detto i ricercatori.
I ricercatori hanno ipotizzato che l’incidenza di lesioni cardiache associate al vaccino fosse più diffusa di quanto si pensasse in precedenza a seguito della vaccinazione di richiamo dell’RNA messaggero a causa della mancanza di sintomi o di sintomi lievi, definendo la lesione come un forte aumento della troponina T cardiaca ad alta sensibilità il terzo giorno dopo la vaccinazione senza evidenza di una causa alternativa.
I livelli di troponina cardiaca dovevano raggiungere il limite superiore della norma, 8,9 nanogrammi per litro nelle donne e 15,5 nanogrammi per litro negli uomini.
A tutti i lavoratori dell’ospedale universitario di Basilea programmati per ricevere un richiamo di siero mRNA per la prima volta è stata offerta la possibilità di partecipare allo studio, a meno che non abbiano avuto un evento cardiaco o siano stati sottoposti a intervento chirurgico al cuore entro 30 giorni dalla vaccinazione. I lavoratori hanno ricevuto un richiamo, che è la metà del livello di dosaggio delle iniezioni della serie primaria, dal 10 dicembre 2021 al 10 febbraio 2022. La coorte è risultata essere di 777 lavoratori, di cui 540 donne. L’età media era di 37 anni.
Tra i partecipanti, 40 avevano livelli elevati di troponina cardiaca. Cause alternative sono state identificate in 18. Per gli altri 22, i ricercatori hanno determinato che avevano «lesioni miocardiche associate al vaccino». L’età media dei 22 era 46. Tutti tranne due erano donne, rendendo la percentuale di donne con livelli elevati superiore alla percentuale di uomini (3,7% contro 0,8%), che contrasta con la maggior parte della letteratura precedente sulla miocardite indotta da vaccino. Ciò potrebbe derivare dal fatto che le donne fanno una dose di vaccino più elevata per peso corporeo, hanno detto i ricercatori.
I livelli basali non sono stati registrati perché la task force COVID-19 dell’ospedale e i ricercatori hanno deciso che lo studio «dovrebbe interferire il meno possibile con la motivazione del personale ospedaliero a ottenere la prima vaccinazione di richiamo mRNA e la logistica della stessa vaccinazione di richiamo».
Nessuna delle persone con marcatori elevati aveva una storia di malattie cardiache. Mentre la metà manifestava sintomi, la maggior parte dei sintomi erano aspecifici come la febbre. Due partecipanti soffrivano di dolore toracico. E due, secondo la definizione del caso della Brighton Collaboration, probabilmente soffrivano di miocardite.
I ricercatori non sono stati in grado di capire il meccanismo per cui il vaccino danneggia il muscolo cardiaco.
Gli autori hanno segnalato alcuni conflitti di interesse, tra cui il dottor Muller che ha riferito di sovvenzioni da produttori di farmaci come Novartis e Roche. Lo studio è stato finanziato dall’Università di Basilea e dall’Ospedale universitario di Basilea.
I limiti dello studio includono la mancanza di livelli basali e la mancanza di imaging, nonostante l’imaging sia raccomandato da molti cardiologi in caso di sospetta miocardite indotta da vaccino.
Diversi altri studi prospettici esaminano la miocardite dopo la vaccinazione Pfizer. In Tailandia, i ricercatori hanno scoperto che il 29% di 301 adolescenti ha sviluppato effetti cardiovascolari, incluso dolore al petto, dopo una seconda dose di Pfizer. A sette è stata diagnosticata un’infiammazione cardiaca.
Come riportato da Renovatio 21, la scorsa settimana l’esercito americano ha confermato il picco di casi di miocardite con la campagna di vaccinazione delle truppe.
La miocardite, che alcuni ritengono che in forma migliore può essere causata anche dall’infezione di COVID-19, è una malattia che può portare alla morte. Casi certificati di morti per miocardite da vaccino mRNA si sono avuti sia tra giovani che tra bambini piccoli.
La consapevolezza del ruolo del vaccino nella possibile manifestazione di questa malattia cardiaca, specie nei giovani, è diffusa presso praticamente tutte le istituzioni sanitarie dei Paesi del mondo.
Disturbo fino a poco fa abbastanza raro, abbiamo visto incredibili tentativi di normalizzare la miocardite infantile con spot a cartoni animati.
Come riportato da Renovatio 21, la miocardite nello sport è oramai un fenomeno impossibile da ignorare.
Salute
Il figlio di Lebron James ha un attacco di cuore durante l’allenamento

Bronny James, il figlio di 18 anni del giocatore liberale della NBA LeBron James, ha subito un arresto cardiaco ieri durante l’allenamento con la squadra di basket della University of Southern California (USC), secondo TMZ Sports. Non è noto se abbia ricevuto l’iniezione di COVID-19.
Secondo quanto riferito, l’atleta è stato portato d’urgenza in un vicino ospedale dopo aver perso i sensi mentre si allenava con la sua squadra maschile lunedì mattina. Una chiamata di emergenza è stata effettuata alle 9:26 di lunedì 24 luglio dal Galen Center dell’USC. Sul posto è arrivata un’ambulanza a sirene spiegate. Il James aveva terminato la scuola a maggio.
Un portavoce della famiglia James ha rilasciato una dichiarazione: «ieri mentre si allenava Bronny James ha subito un arresto cardiaco. Il personale medico è stato in grado di curare Bronny e portarlo in ospedale. Ora è in condizioni stabili e non più in terapia intensiva. Chiediamo rispetto e privacy per la famiglia James e aggiorneremo i media quando ci saranno maggiori informazioni».
La notizia del malore del giovane cestista ha spinto molti sui social media a chiedersi se fosse correlato al vaccino sperimentale COVID, poiché le segnalazioni di atleti professionisti completamente vaccinati che hanno avuto problemi cardiaci e persino la morte sono salite alle stelle negli ultimi anni.
Non è noto lo status vaccinale del giovane, tuttavia lo è quello del padre, che nel 2021 ha fatto dichiarazioni a riguardo includendo la sua famiglia: «All’inizio ero scettico … ma ho fatto le mie ricerche», aveva detto davanti alle telecamere, per poi precisare di aver deciso per il vaccino «per la mia famiglia e per i miei amici, ecco perché ho deciso di farlo».
For those who are asking…We do not yet know if Bronny got the vaccine. But is father, LeBron James, did. pic.twitter.com/kST7GWCXIf
— DiedSuddenly (@DiedSuddenly_) July 25, 2023
«Non possiamo attribuire tutto al vaccino, ma, per lo stesso motivo, non possiamo attribuire nulla», ha scritto su Twitter Elon Musk. «La miocardite è un noto effetto collaterale. L’unica domanda è se sia raro o comune».
"Yesterday while practicing Bronny James suffered a cardiac arrest. Medical staff was able to treat Bronny and take him to the hospital. He is now in stable condition and no longer in ICU. We ask for respect and privacy for the James family and we will update media when there is… pic.twitter.com/3Ah4Rt4dJx
— Chief Nerd (@TheChiefNerd) July 25, 2023
Il problema della miocardite sportiva globale, scoppiato per qualche motivo proprio nel 2021 (statisticamente l’anno con più calciatori morti sul campo), sta continuando.
Il Basket aveva visto il caso di Imo Essien, giocatore del prestigioso campionato universitario NCAA, crollato sul parquet in partita.
Tuttavia potrebbe trattarsi della punta dell’iceberg. Un ex campione dell’NBA, John Stockton, per anni in forze agli Utah Jazz, ha dichiarato la settimana scorsa che «gli atleti morti a causa del vaccino COVID potrebbero essere migliaia».
Immagine di Foxlifevisuals via Wikimedia pubblicata su licenza Creative Commons Attribution-ShareAlike 4.0 International (CC BY-SA 4.0)










